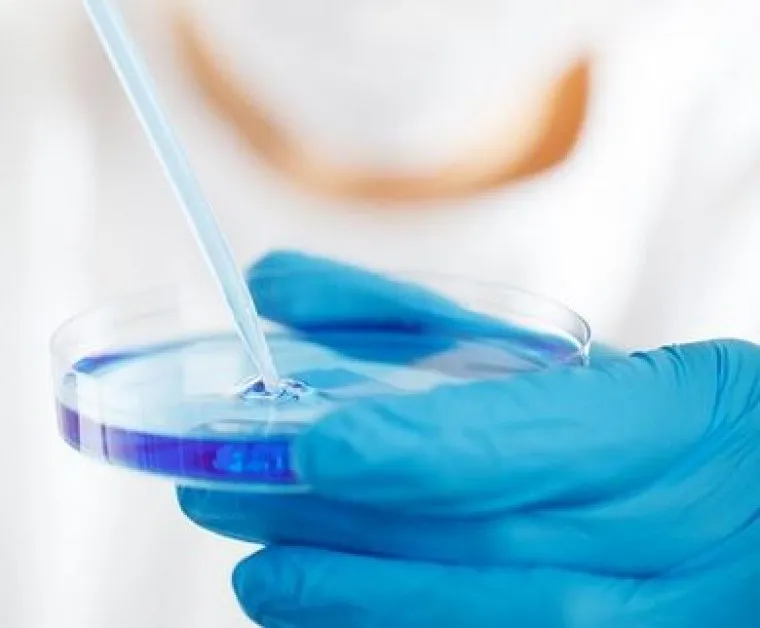

Учени са открили съществени прилики между рака на млечната жлеза при котките и рака на гърдата при хората – откритие, което потенциално може да доведе до нови терапии и за двата вида.
Въпреки че ракът е една от водещите причини за заболявания и смърт при котките, досега се знаеше сравнително малко за неговата генетична основа, пише Newsweek.
В ново проучване експерти от Института „Уелкъм Сангър“, Ветеринарния колеж на Онтарио в Канада, Университета в Берн и техни партньори са идентифицирали генетични промени, които биха могли да подпомогнат лечението както при котки, така и при хора.
Изследователите са анализирали близо 500 домашни котки от пет държави, като са сравнили генетичните изменения с тези, наблюдавани при хората. Чрез секвениране на ДНК от тъканни проби, събрани предварително от ветеринарни лекари за диагностични цели, учените установили, че при някои видове тумори генетичните промени, които задвижват развитието на рака при домашните котки, са сходни с тези при хората.
„Нашите домашни любимци споделят същата среда като нас, което означава, че са изложени на същите фактори на околната среда“, заявява проф. Джефри Ууд от Ветеринарния колеж на Онтарио.
По думите му това може да помогне за по-добро разбиране на причините за развитието на рак при котки и хора, както и за откриване на нови начини за превенция и лечение.
В рамките на проучването – първото мащабно генетично профилиране на котешки тумори – учените са изследвали около 1000 гена, свързани с рака при хората, в туморни и здрави тъканни проби. Анализирани са 13 различни вида рак при котки, които са сравнени с онкологични заболявания при хора и кучета.
„Като сравняваме геномиката на рака при различни видове, получаваме по-дълбоко разбиране за причините за заболяването“, посочва Бейли Франсис от Института „Уелкъм Сангър“.
Проучването идентифицира седем т.нар. „движещи“ гена, чиито мутации водят до развитие на рак. Най-често срещаният е генът FBXW7 – при над 50% от изследваните котешки тумори е установена промяна в него. При хората измененията в този ген при рак на гърдата се свързват с по-лоша прогноза.
Друго важно откритие е, че някои химиотерапевтични лекарства са по-ефективни при котешки тумори с мутации в гена FBXW7.
Вторият най-често срещан „движещ“ ген е PIK3CA – установен в 47% от котешките тумори на млечната жлеза. Същата генетична промяна се наблюдава и при рак на гърдата при хора, където се лекува с т.нар. PI3K инхибитори.
Сходства с човешките мутации са установени и при тумори на кръвта, костите, белите дробове, кожата, стомашно-чревния тракт и централната нервна система.
Изследователите смятат, че успешни терапевтични подходи, прилагани при хора, могат да бъдат изпробвани и при котки. Това е част от концепцията „Една медицина“ – подход, който насърчава обмена на данни и знания между хуманната и ветеринарната медицина в полза както на хората, така и на животните.
„Това е едно от най-големите постижения в котешката онкология досега и означава, че генетиката на туморите при домашните котки вече не е „черна кутия““, заявява д-р Луиз ван дер Вейден от Института „Уелкъм Сангър“.
По думите ѝ следващата стъпка е развитието на прецизна котешка онкология, която да достигне нивото на диагностичните и терапевтични възможности, налични при кучета, а в бъдеще – и при хора.
Прочетете още
- 12:24 Извънредна ситуация на АМ "Тракия"* СНИМКИ+ВИДЕО
- 10:53 София под вода: Пороен дъжд наводни улици, паркинги и блокира трафика ВИДЕО
- 12:05 Две минути тишина за един народ: Защо сирените на 2 юни все още ни карат да настръхваме
- 11:23 Отиде си Любен Дилов-син. Замлъкна един от най-острите гласове на България